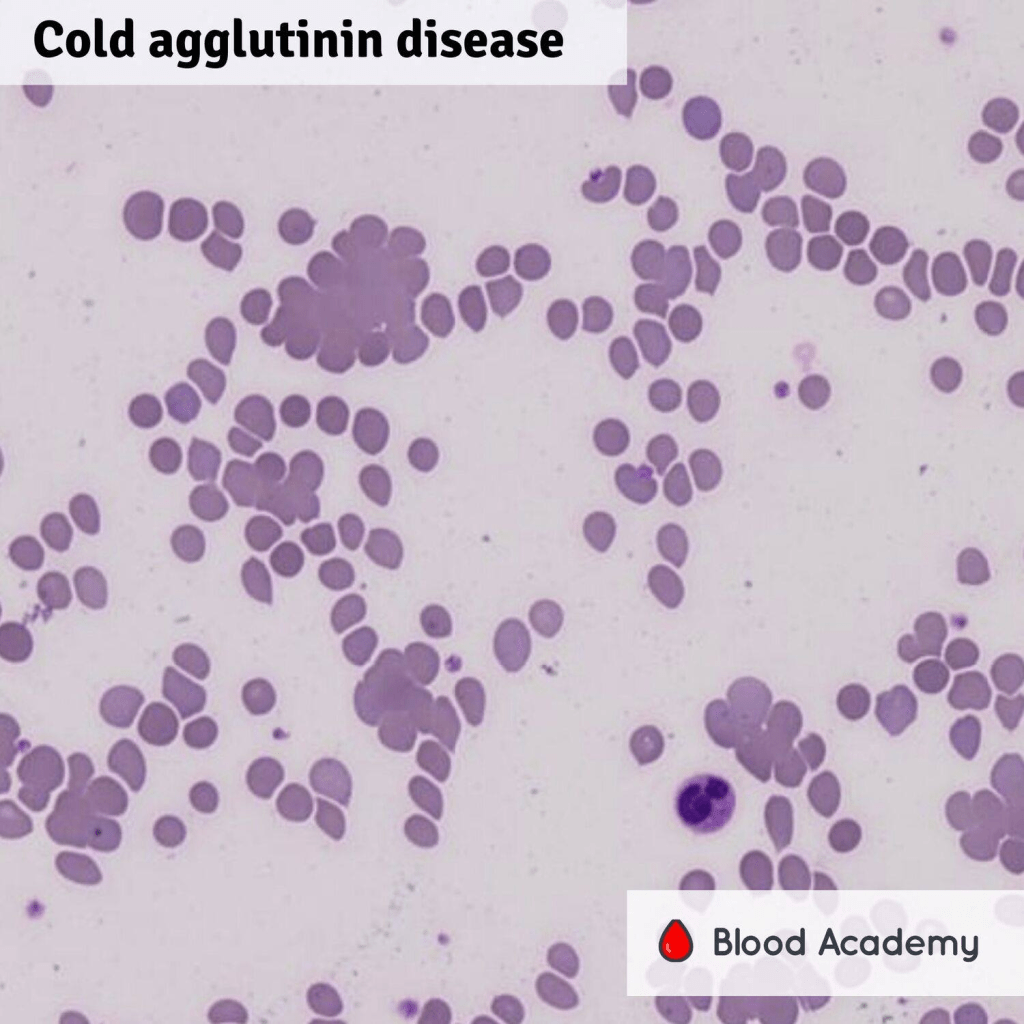

What is CAD?:
CAD is a rare autoimmune hemolytic anemia where the immune system mistakenly “tags” red blood cells for destruction. This process is uniquely triggered by cold temperatures (typically 3-4 degrees Celsius), causing red blood cells to perish much faster than their normal 120-day lifespan. Primarily affecting adults between 40 and 80, the disorder results in the bone marrow’s inability to keep pace with cell loss, leading to chronic anemia and its associated symptoms like fatigue, dizziness, and heart palpitations.
Beyond general weakness, the rapid breakdown of cells releases hemoglobin and bilirubin into the system, which can cause jaundice and dark-colored urine. Physical exposure to the cold can also trigger painful skin discolorations in the extremities, such as Raynaud’s sign. Management of CAD focuses on lifestyle adjustments to avoid cold exposure, treating any underlying causes, and using medications to suppress the immune response and stabilize red blood cell counts.
Symptoms:

CAD primarily affects adults between the ages of 40 and 80, with symptoms typically manifesting through hemolysis or circulatory issues triggered by cold exposure. While some individuals with mild cases remain asymptomatic, others may experience standard signs of anemia such as fatigue, dizziness, and palpitations. In more severe, rapid cases of cell destruction, patients may face serious complications like chest pain, confusion, or hemodynamic instability. The breakdown of red blood cells also releases hemoglobin and bilirubin, often resulting in dark-pigmented urine and jaundice.
Beyond internal cell destruction, CAD frequently causes visible circulatory distress in the extremities. This includes coldness and painful skin discoloration, such as Raynaud phenomenon or acrocyanosis, which in extreme instances can lead to skin ulcers. Although CAD is a chronic condition and may carry an increased risk of blood clots, it is often self-limiting, especially when linked to temporary infections. Generally, it does not significantly reduce a person’s overall life expectancy.
Causes:

CAD is driven by the immune system’s production of autoantibodies, most commonly the IgM class, which mistakenly targets healthy red blood cells. These antibodies become active in cold temperatures, causing the red blood cells to agglutinate. This “tagging” process triggers the complement system, a part of the immune response that recruits specialized cells, such as macrophages, to attack and destroy the red blood cells prematurely.
In many instances, CAD does not occur in isolation but rather as a secondary disorder linked to an underlying health issue. In fact, an underlying cause may be present in up to 70% of cases. These triggers range from viral and bacterial infections to more complex conditions like immunoproliferative diseases, including certain leukemias and lymphomas, or connective tissue disorders like lupus and rheumatoid arthritis.
Diagnosis:

The diagnosis of CAD follows a systematic clinical pathway, beginning with the identification of hemolytic anemia through standard blood panels. Initial indicators include low hemoglobin and hematocrit levels paired with a high reticulocyte count, as the body attempts to compensate for premature cell loss. Laboratory markers specifically pointing to hemolysis include elevated bilirubin and lactate dehydrogenase (LDH), alongside depleted levels of haptoglobin, a protein consumed when scavenging released hemoglobin.
To confirm the autoimmune nature of the condition, clinicians utilize the Coombs test. While this test specifically detects the presence of the C3 complement on red blood cells in CAD patients, further specialized testing is required to verify the “cold” aspect of the disorder. This includes a thermal amplitude test to measure antibody reactivity at varying temperatures and a titer test, which determines the concentration of cold agglutinins by progressively diluting the patient’s serum. Once CAD is confirmed, the final diagnostic step involves a comprehensive evaluation to identify any secondary underlying triggers, such as infections or other blood disorders, to ensure a targeted treatment approach.
Treatment:

Managing CAD begins with strict lifestyle adjustments, primarily the avoidance of cold exposure to the face, head, and extremities to prevent triggering hemolysis. In clinical settings, this may even require prewarming intravenous fluids. For many patients with mild symptoms, active monitoring is sufficient; however, if red blood cell destruction accelerates, pharmacological intervention becomes necessary. The primary first-line treatment is rituximab, a monoclonal antibody that targets the white blood cells responsible for producing harmful autoantibodies. While effective, rituximab is often combined with chemotherapy agents like fludarabine or bendamustine to improve results, though relapses remain common.
In acute or life-threatening situations, such as severe anemia or rapid hemolysis, temporary measures like blood transfusions or plasma exchange may be utilized. Plasma exchange works by physically removing circulating autoantibodies from the blood, while transfusions provide immediate cell replacement. Both require specialized temperature-controlled protocols to avoid worsening the condition. Ultimately, if CAD is secondary to another illness, treating that underlying trigger is essential for long-term management, as transfusions and plasma exchanges only offer short-term stabilization rather than a permanent cure.
How You Can Make an Impact:
Without proper research, funding, and support for continued studies and clinical trials to determine possible cures, legitimate medicines for the disease, or preventative treatment, many more people will go on to develop CAD. If you can, please donate here! If you are unable to donate, consider volunteering your time by raising awareness for this rare disease. If you’re interested in learning more about CAD, donation opportunities, or the progress being made on potential treatments, visit the Cold Agglutinin Disease Foundation. The Cold Agglutinin Disease Foundation “is dedicated to the advancement of knowledge about Cold Agglutinin Disease for the medical profession, patients and care partners.”
Let’s keep spreading awareness! – Lily
References:
Leveille, E., & Brugnara, C. (2024, September 9). Cold Agglutinin Disease – Symptoms, Causes, Treatment | NORD. NORD (National Organization for Rare Disorders). https://rarediseases.org/rare-diseases/cold-agglutinin-disease/
Leave a comment